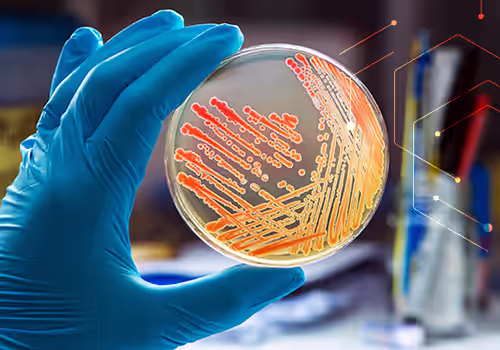

Answers to Tough Questions About Demonstrating Personnel Competency under USP 797
- By: Rhonda Lintner, MPH, B.S.
- Tags: USP 797
The 2023 revisions to USP <797> reshaped how compounding pharmacies need to think about a variety of critical practices, including personnel competency, gloved fingertip testing (GFT), and beyond‑use dating. This post takes a practical look at those changes, focusing on how the new CSP categories drive competency schedules, how personnel competency revisions impact response, and what your options are when GFT or aseptic manipulation results are less than perfect.
A Quick Review: CSP Categories in USP <797>
Since many aspects of USP <797> adherence are influenced by the revised CSP categories, let’s quickly review how CSP classifications have changed. Instead of the familiar low, medium, and high-risk categories, the standard now uses Categories 1, 2, and 3.
Category 1 CSPs are compounded under the least controlled environmental conditions and may be prepared either in a segregated compounding area (SCA) or in a cleanroom suite, as long as all Category 1 requirements are met. Because the surrounding environment is less controlled and these CSPs are intended for shorter storage periods, they are limited to a beyond‑use date (BUD) of no more than 12 hours at controlled room temperature or 24 hours under refrigeration.
Category 2 CSPs must be prepared in a cleanroom suite, typically using an ISO Class 5 primary engineering control (PEC) located in an ISO Class 7 buffer room with an associated ante‑area, and in compliance with all applicable Category 2 requirements. With these stronger environmental controls, testing, and procedures in place, Category 2 CSPs may be assigned BUDs longer than 12 hours at controlled room temperature or 24 hours refrigerated, up to the specific limits listed in USP 797 Table 13.
Category 3 CSPs meet all Category 2 requirements and additional, more stringent criteria, including more frequent personnel qualification, use of sterile garb, enhanced cleaning with sporicidal agents, increased environmental monitoring, and required sterility testing (with endotoxin testing when applicable) supported by stability data. When all Category 3 conditions are satisfied, these CSPs may be assigned BUDs longer than those allowed for Category 2—up to the maximum time frames specified in USP 797 Table 14, which can extend to periods of several months for certain preparations.
It’s important to understand that the change in categories is more than just a change in naming conventions. Conceptually, it is a move away from categorization based on the complexity of the preparation and toward the level of control over contamination risk and product stability. The old low/medium/high framework largely emphasized process complexity. The new approach aligns the classification system more closely with real-world contamination risk and modern compounding practices.
From Risk Levels to Categories: What It Means for Competency Schedules
Under the revised USP <797> standard, the initial frequency for garbing competency remains the same: Compounders and their direct supervisors must still successfully complete three consecutive GFT assessments with zero CFU before compounding independently. However, ongoing testing frequency is now aligned with the new CSP categories. Personnel who compound Category 1 and 2 CSPs must complete GFT at least every 6 months, while those who compound Category 3 CSPs must do so at least every 3 months.
In practice, this change means that many sites that previously performed GFT annually for low- and medium-risk compounding will now need to test more frequently, particularly if they prepare Category 3 CSPs. Compounding pharmacies should review and adjust their competency schedules and media procurement to match the CSP categories prepared at their facility.
It is also important to remember that USP <797> is a standard of minimums, not best practices. The phrase “at least” is intentional: it sets a baseline and gives each pharmacy the responsibility to tighten schedules when their data suggest a higher level of control is needed. A site may choose to perform GFT quarterly for Category 1 and 2 CSPs—or even more often for high‑volume or high‑risk workflows.
Trending and genus identification can also play a key role in deciding whether the baseline specified in the standard is truly sufficient. If positive results begin to creep upward over time, or if multiple staff members show sporadic positives, the pharmacy may want to consider shortening competency assessment intervals while it investigates the cause and retrains personnel.
One Competency, One Failure
Under the 2022 revisions to USP <797>, the personnel competency is also more structured. The core elements with a laboratory testing requirement, such as garbing, gloved fingertip sampling, aseptic technique, media-fill testing, and surface monitoring, are familiar but they are now organized into two distinct, named competencies with explicit pass/fail rules and testing frequencies.
Garbing and hand hygiene focuses on proper gowning/garbing technique plus gloved fingertip and thumb sampling performed after garbing.
Aseptic manipulation is a bundled assessment that includes visual observation of aseptic technique, a media-fill test, post–media-fill gloved fingertip sampling, and surface sampling of the direct compounding area.
This bundling effectively creates a “one competency, one failure” rule. If any portion of the aseptic manipulation evaluation fails—whether media fill, gloved fingertip test, or surface sampling—the entire assessment must be repeated. Consider this real‑world scenario:
A hospital compounding pharmacy completes its routine aseptic manipulation competency, including a media fill, post–media-fill gloved fingertip sampling, and post–media-fill surface sampling. When the results come back, only the post–media-fill gloved fingertip test has failed. Ordering a new media-fill kit, repeating the full incubation period, and re‑doing all three elements can be time‑consuming and expensive, so the pharmacy team naturally wonders if they can repeat only the failed gloved fingertip test instead of the entire aseptic‑technique bundle.
Under the current USP <797> standard, the answer is “no.” These three elements together constitute a single aseptic manipulation competency. A failure in any single component (media fill, post–media-fill gloved fingertip, or surface sample) counts as a failure of the entire competency, and the pharmacy must repeat the full set of tests, not just the one that failed.
Documenting Your “Gray Area” Decisions
USP 797 gives you clear minimums for when and how often to test, as a standard of minimums, it leaves a few grey areas. This is where your own protocols and the way you document them become critical. Surveyors are trained to ask tough questions and will be looking to determine that you (1) anchored your decision in the standard, (2) are aligned to a facility-specific risk assessment, (3) created a defined, written decision pathway, and (4) followed it consistently and completely.
For each pathway, specify who makes the decision, what data they must review, and how the final call is documented. Then treat every event like a mini case study: record the trigger, the investigation, the conclusion, and the exact actions you took, including any BUD changes, retraining, or added monitoring.
While this level of documentation may sound time‑consuming, predefined SOPs go a long way toward turning tough decisions into well‑defined, defensible practices that take less time to document when events occur. This level of care also demonstrates control of your processes and a consistent focus on patient safety, giving surveyors greater confidence in your operations.
Your Partner in Performance
If you are re-evaluating USP <797> strategy, you do not have to navigate the details alone. Pace® offers accredited microbiology testing, method guidance, and practical support to help align your competency program, environmental monitoring, and documentation with current standards. From designing sampling plans and interpreting action levels to troubleshooting unexpected failures, our team can serve as an extension of your pharmacy’s quality program. Contact us to get the conversation started.
